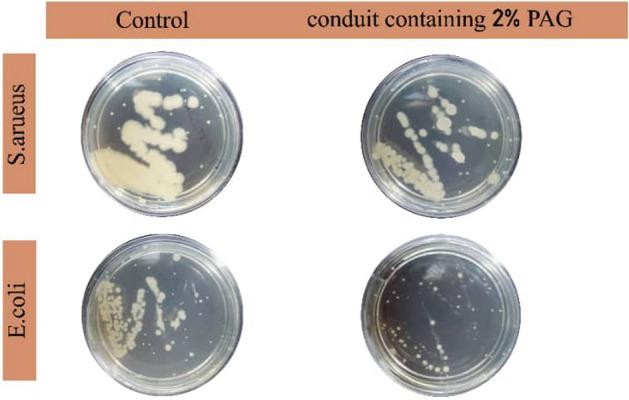
https://cdn.ncbi.nlm.nih.gov/pmc/blobs/b21d/10368663/c5114eb4eba2/41598_2023_38456_Fig6_HTML.jpg

具有压电性能的神经传导导管促进 PC12 分化。
Conductive nerve conduit with piezoelectric properties for enhanced PC12 differentiation.
机构信息
Department of Biomedical Engineering, Science and Research Branch, Islamic Azad University, Tehran, Iran.
Chemical and Petroleum Engineering Department, Sharif University of Technology, Tehran, Iran.
出版信息
Sci Rep. 2023 Jul 25;13(1):12004. doi: 10.1038/s41598-023-38456-4.
Restoration of nerve tissue remains highly challenging, mainly due to the limited regeneration capacity of the nervous system and the development of fibrosis. This limitation necessitates designing new nerve guidance channel to promote nerve repairing. In this study, we developed a novel core/shell conduit to induce PC12 differentiation. Co-electrospinning method was utilized to produce a fibrous shell containing polycaprolactone/polyvinylidene fluoride PCL/PVDF, gelatin and polyaniline/graphene (PAG) nanocomposite. The core section of the conduit was filled with chitosan-gelatin hydrogel containing PAG and ZnO nanoparticles. Such conduit shows antibacterial activity, electrical conductivity and piezoelectric property. The effect of such engineered conduit on PC12 differentiation was investigated by analyzing differentiation markers Nestin and microtubule-associated protein 2 (MAP2) through immunocytochemistry and PCR-RT techniques. The result revealed that such conduit could significantly induce Nestin and MAP2 gene expression in the PC12 cells and, thus, it is a viable option for effective cell differentiation and nerve regeneration.
神经组织的修复仍然极具挑战性,主要是由于神经系统的再生能力有限和纤维化的发展。这一限制需要设计新的神经引导通道来促进神经修复。在这项研究中,我们开发了一种新型的核/壳导管来诱导 PC12 分化。共静电纺丝方法用于制备含有聚己内酯/聚偏二氟乙烯(PCL/PVDF)、明胶和聚苯胺/石墨烯(PAG)纳米复合材料的纤维状外壳。导管的芯部填充了含有 PAG 和 ZnO 纳米粒子的壳聚糖-明胶水凝胶。这种导管具有抗菌活性、导电性和压电性能。通过免疫细胞化学和 PCR-RT 技术分析分化标志物巢蛋白和微管相关蛋白 2(MAP2),研究了这种工程导管对 PC12 分化的影响。结果表明,这种导管可以显著诱导 PC12 细胞中巢蛋白和 MAP2 基因的表达,因此它是一种有效的细胞分化和神经再生的选择。